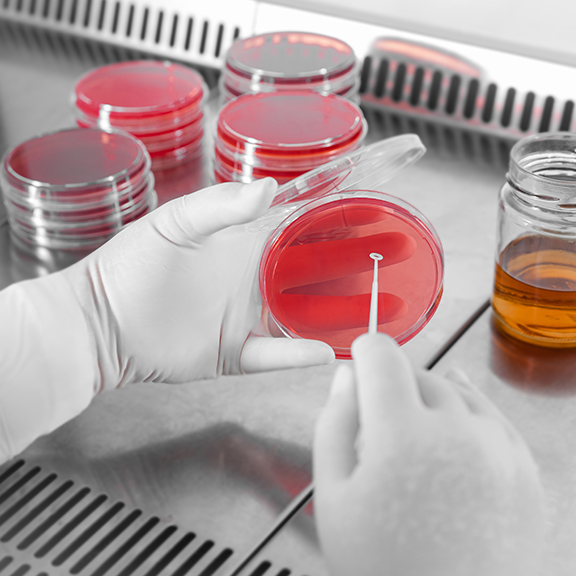

Her hasta modern tedavi alma şansını ve yüksek yaşam kalitesini hak eder" ilkesi ile yola çıkan Ar-Ge Merkezimiz için insan ve kalite en önemli kilometre taşlarıdır. Ar-Ge Merkezimizin bir diğer önemli rolü de yenilikçi kültürün kurum içinde yayılması ve entegre edilmesidir. Tüm geliştirme çalışmaları, yasal, bilimsel ve Centurion'un etik kurallarına uyan alt bölümler altında örgütlenmiş uzman ekipler tarafından gerçekleştirilmektedir.
İlaç sektöründe Ar-Ge süreci, araştırmanın başlatılmasından ruhsatın alınması ve pazara verilmesine kadar olan dönemi kapsamaktadır. İlaç sektöründe Ar-Ge faaliyetleri en fazla katma değere sahip, fakat aynı zamanda maliyeti çok yüksek olan faaliyetlerdir. İlaç geliştirme süreci, yüksek maliyetine ek olarak uzun zaman alan ve riskli bir süreçtir. Centurion, Ar-Ge çalışmaları için, toplumun ihtiyaçlarını karşılamaya yetkin, tutarlı, çağdaş, bilimsel ve teknik bir yaklaşımla çalışan iyi organize edilmiş bir ortam yaratmış ve sürdürülmektedir.

Ar-GE departmanımız; firmamızın Türkiye'nin önde gelen eşdeğer ilaç üreticilerinden biri olması, rekabetçi konumunu güçlendirmesi ve geliştirmesi için önemli bir rol oynamaktadır. Ar-Ge çalışmalarıyla hedefimiz; bu amaç doğrultusunda sürekli gelişen Ar-Ge faaliyetleri ile Centurion'un özen ve kalite stratejisini harmanlayarak, Türk ve Avrupa ilaç pazarının liderleri arasında olmaktır. Centurion'un Ar-Ge süreçleri ve teknolojileri, geliştirilmesi planlanan hastane jeneriği ve biyobenzer ürünler için rekabet avantajı sağlayacak katı bir IP politikasına dayanmaktadır.
Kendi bünyemizdeki bilgi ve beceri ile yenilikçi jenerik ilaçlar ve katma değeri yüksek biyobenzerler geliştirmek önemli hedeflerimiz arasında olup, yeteneklerimiz bize likit ve liyofilize ürünlerde flakon, kullanıma hazır şırınga (PFS) ve kartuş gibi geniş yelpazedeki farklı formları geliştirme seçenekleri sağlamaktadır..